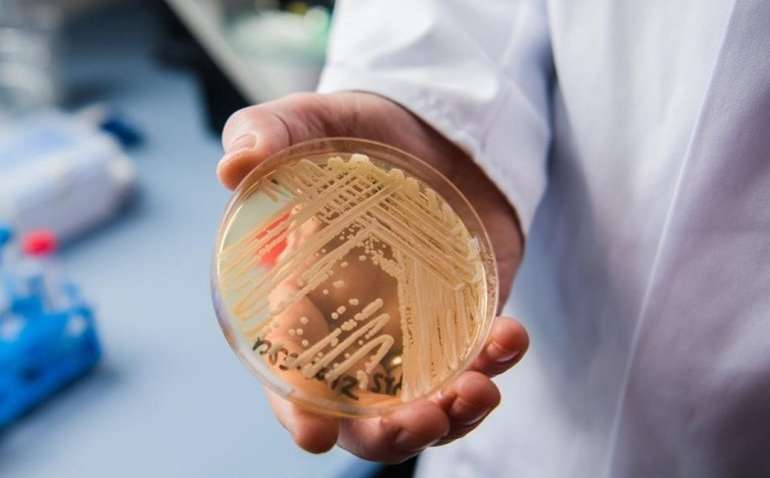
Глобальное потепление породило смертоносную инфекцию - установили ученые

Рубрики
МЕНЮ
Глобальное потепление породило смертоносную инфекцию - установили ученые
Вспышки грибковой инфекции были зарегистрированы в более чем 30 странах

Олеся Солдатенко
Неизвестный грибок, который появился одновременно в трех разных уголках земного шара, что не удается выделить в дикой природе, умеет жить внутри нашего тела, а заражение им часто заканчивается летальным исходом.
Три года назад представители здравоохранения предупредили сотни тысяч клиник по всему миру о том, что появился новый, быстро распространяемый и устойчив к большинству препаратов тип дрожжей, который вызвал потенциально смертельные грибковые инфекции у госпитализированных пациентов. "Candida auris" стал серьезной глобальной угрозой здоровью с того времени, как его открыли 10 лет назад, и особенно опасен он для людей с ослабленной иммунной системой.
Вспышки грибковой инфекции были зарегистрированы в более чем 30 странах. На самом деле он распространен еще шире, поскольку его трудно идентифицировать в организме без специализированных лабораторных методов. Грибок устойчив к большинству противогрибковых препаратов и легко может распространяться между пациентами в больницах и других медицинских учреждениях. Результат — заражение крови, сердца или головного мозга. Ранние исследования показывают, что смертность в результате такой инфекции составляет 30-60%, то есть в среднем умирает каждый третий пациент.
Ученые из США и Нидерландов считают, что ключевую роль сыграло глобальное потепление. Более того, Candida auris — это лишь один из примеров появления новых, невероятно опасных инфекционных носителей, с которыми человечеству еще только предстоит столкнуться в результате изменения климата.
Ранее "Комментарии"сообщали, что ученые нашли противоядие от самой ядовитой медузы в мире.
Читайте Comments.ua в Google News
Новости партнеров



